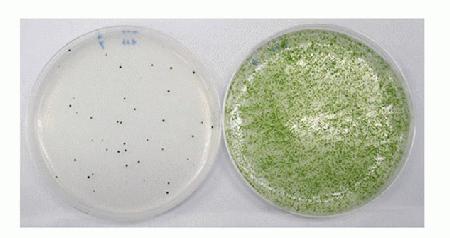

Search
Search
Eight different strains of Chlamydomonas reinhardtii (CC1690, CC2935, CC1009, CC4414, CC118, CC536, WT137c, CC3395 wall(-)) were transformed using MAX Efficiency® Transformation Reagent for Algae or with TAP/sucrose reagent by electroporation. This comparison shows that MAX Efficiency® Transformation Reagent for Algae resulted in >1000 fold more colonies over TAP/sucrose media in C. reinhardtii WT137c.